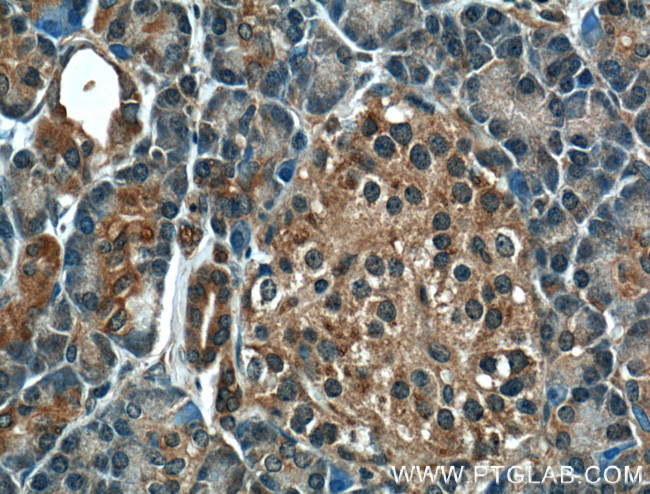
GTPBP2 Antibody in Immunohistochemistry (Paraffin) (IHC (P))

Search
Proteintech
GTPBP2 Polyclonal Antibody
{{$productOrderCtrl.translations['antibody.pdp.commerceCard.promotion.promotions']}}
{{$productOrderCtrl.translations['antibody.pdp.commerceCard.promotion.viewpromo']}}
{{$productOrderCtrl.translations['antibody.pdp.commerceCard.promotion.promocode']}}: {{promo.promoCode}} {{promo.promoTitle}} {{promo.promoDescription}}. {{$productOrderCtrl.translations['antibody.pdp.commerceCard.promotion.learnmore']}}
产品信息
11557-1-AP
种属反应
宿主/亚型
分类
类型
抗原
偶联物
形式
浓度
规格
纯化类型
保存液
内含物
保存条件
运输条件
产品详细信息
Immunogen sequence: SKMITFIDL AGHHKYLHTT IFGLTSYCPD CALLLVSANT GIAGTTREHL GLALALKVPF FIVVSKIDLC AKTTVERTVR QLERVLKQPG CHKVPMLVTS EDDAVTAAQQ FAQSPNVTPI FTLSSVSGES LDLLKVFLNI LPPLTNSKEQ EELMQQLTEF QVDEIYTVPE VGTVVGGTLS SGICREGDQL VVGPTDDGCF LELRVCSIQR NRSACRVLRA GQAATLALGD FDRALLRKGM VMLSPEMNPT ICSVFEAEIV LLFHATTFRR GFQVTVHVGN VRQTAVVEKI HAKDKLRTGE KAVVRFRFLK HPEYLKVGAK LLFREGVTKG IGHVTDVQAI TAGEAQANMG F (183-532 aa encoded by BC028347)
靶标信息
Small G proteins act as molecular switches for regulation of variety of cellular processes, such as nuclear transport, signal transduction, membrane trafficking and protein synthesis. GTPBP2 (GTP-binding protein 2) is a 602 amino acid G protein that is expressed in kidney, skeletal muscle, testis, brain and thymus, though it is not detected in liver. Expression of GTPBP2 is enhanced by ©-interferon stimulation in HeLa cells, THP-1 cells and thioglycollate-elicited mouse peritoneal macrophages. There are four isoforms of GTPBP2 that are expressed as a result of alternative splicing events. Since mutation of the gene encoding GTPBP1 does not lead to any phenotypic abnormalities, it is thought that there may be a genetic redundancy to make up for GTPBP1 lack-of-function. GTPBP2 shares 44% sequence similarity with GTPBP1 and also overlaps in expression pattern, suggesting that the GTPBP2 gene may compensate for GTPBP1 genetic abnormalities.
仅用于科研。不用于诊断过程。未经明确授权不得转售。
篇参考文献 (0)
生物信息学
蛋白别名: GTP-binding protein 2; GTP-binding-like protein 2; GTPBP2; unnamed protein product
基因别名: GTPBP2; JABELS; nmf205
UniProt ID: (Human) Q9BX10, (Mouse) Q3UJK4
Entrez Gene ID: (Human) 54676, (Mouse) 56055, (Rat) 363195